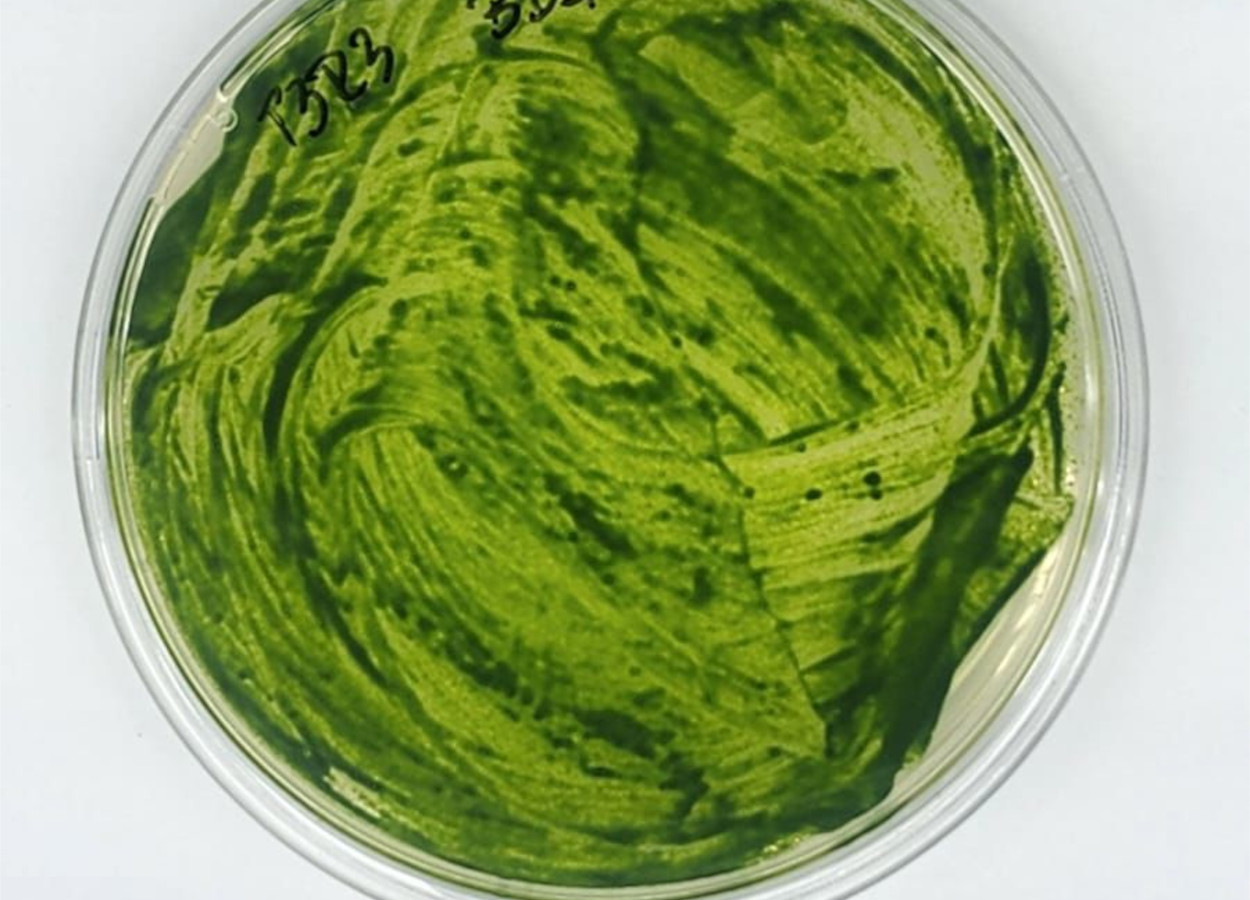

Como a industrialização transformou o cooperativismo em SC
Por Vanir Zanatta, presidente da Organização das Cooperativas do Estado de Santa Catarina (Ocesc)
A agricultura tem passado por transformações significativas nas últimas décadas. Demandas por produtividade no setor agrícola têm aumentado com a finalidade de suprir as necessidades da crescente população mundial, garantindo principalmente a segurança alimentar.
Por outro lado, a perspectiva global na agricultura vem sendo modificada e a busca por práticas sustentáveis e ecológicas tem se intensificado diante dos possíveis impactos negativos gerados ao ambiente, principalmente, devido às atividades antrópicas e uso inadequado de recursos naturais (Pereira et al., 2022).
O uso de bioinsumos tem se destacado como uma alternativa eficiente aos insumos convencionais, podendo impactar positivamente a produção agrícola (Souza; Castilho; Macedo, 2022; Silva et al., 2024). Com isso, políticas públicas promovem o incentivo de práticas e tecnologias biológicas na agricultura, como o Programa Nacional de Bioinsumos, um dos mais significativos, pois fomenta o uso de produtos biológicos, que influenciam no desenvolvimento de animais, plantas e microrganismos (Brasil, 2020; Souza; Castilho; Macedo, 2022).
O uso de insumos biológicos cresce rapidamente na agricultura moderna. Em 2023, mais de 55% das lavouras brasileiras adotaram algum bioinsumo, cobrindo 36% da área cultivada (84 milhões de hectares) (Camargo, 2024; Romanelli, 2024).
A demanda por soluções sustentáveis deve impulsionar novas pesquisas e ampliar o mercado, que pode atingir US$ 4,76 bilhões e 43,23 milhões de hectares até 2028 (Inkwood Research, 2023; Borges, 2025).
Entre os insumos biológicos agrícolas, as algas destacam-se como alternativa promissora, mas ainda requerem estudos mais aprofundados sobre suas interações no sistema solo-planta (Khan et al., 2009). Sua aplicação enfrenta desafios como produção em larga escala, falta de padronização industrial, altos custos, entraves logísticos, risco de contaminação e escassez de pesquisas de alta qualidade (Abinandan; Shanthakumar, 2015).

As algas, majoritariamente fotossintetizantes, adaptam-se a condições extremas e ocorrem em praticamente todos os biomas desde os primórdios da vida na Terra (Craigie, 2011). São fontes naturais de compostos bioativos como lipídios, minerais, fitormônios, aminoácidos, carboidratos e substâncias antibacterianas (Craigie, 2011).
Entre os gêneros mais conhecidos estão Chlorella, Spirulina (Arthrospira), Kappaphycus, Lithothamnion, Dunaliella, Scenedesmus, Navicula, Nostoc, Anabaena e Ascophyllum (Parmar et al., 2023), incluindo cianobactérias, procariontes fotossintetizantes (Ortiz-Moreno; Sandoval-Parra; Solarte-Murillo, 2019).
Extratos de algas atuam como bioestimulantes, fornecendo fitohormônios como auxinas, citocininas e giberilinas, aumentando a eficiência no uso de nutrientes, estimulando raízes, promovendo crescimento vegetativo e induzindo resistência a estresses por meio de rotas como rotas de sinalização (ácido salicílico, jasmonato e etileno) (Chemik, 2013; Jardin, 2015; Shukla et al., 2019; Ali; Ramsubhag; Jayaraman, 2021; Deolu-Ajayi et al., 2022).
Também potencializam a eficiência de fertilizantes minerais e podem participar da fixação biológica de nitrogênio (FBN). Chlorella, por exemplo, recicla nutrientes, mobiliza fósforo (P) e potássio (K), incrementa a matéria orgânica (MO) e estimula a microbiota do solo (Ortiz-Moreno; Sandoval-Parra; Solarte-Murillo, 2019; Singh et al., 2025).
Durante a mucilagem, algas liberam polissacarídeos que atuam como biocondicionadores, melhorando retenção de umidade, porosidade e reduzindo erosão (Ortiz-Moreno; Sandoval-Parra; Solarte-Murillo, 2019; Mahgoub Shaalan, 2025). Em cana-de-açúcar, Ascophyllum nodosum favorece crescimento e atividade microbiana do solo (Mahgoub Shaalan, 2025).
Adicionalmente, estudos indicam que a aplicação de extratos de microalgas pode aumentar significativamente a taxa de germinação, o crescimento em altura, a biomassa seca da parte aérea, o teor de clorofila e a produtividade de grãos em culturas como milho, trigo e arroz, (Ortiz-Moreno; Sandoval-Parra; Solarte-Murillo, 2019; Alvarez et al., 2021). Entre os compostos presentes nas algas destaca-se a betaína, um soluto que confere maior tolerância a estresses abióticos, como salinidade, déficit hídrico e variações térmicas (Singh et al., 2025).
Algumas espécies também demonstram ação antifúngica e antibacteriana na rizosfera, contribuindo para a proteção contra fitopatógenos. Determinadas cianobactérias formam heterocistos, células diferenciadas de parede espessada, com supressão parcial do Fotossistema II e alta atividade da hidrogenasse, que convertem N2 atmosférico em formas assimiláveis, contribuindo para o suprimento de N às plantas e para a eficiência de uso de N (EUN) em sistemas agrícolas, o que representa uma vantagem agronômica e ambiental significativa (Wolk, 1996; Bothe 2010; Alvarez et al., 2021; Singh et al., 2025).
O nitrogênio (N) é o macronutriente mais exigido pelas plantas, mas cerca de 50% do N aplicado via fertilizantes é perdido, gerando prejuízos econômicos e impactos ambientais, como emissão de GEE e contaminação hídrica (Cassim et al., 2021).
No entanto, o cenário atual é preocupante, onde aproximadamente 60% do aumento recente da contaminação por N provém da agricultura, reforçando a necessidade de tecnologias que melhorem a EUN e reduzam a dependência de fertilizantes minerais (Robertson; Groffman, 2007; Cassim et al., 2021; Jiménez-Ríos, 2024). Nesse contexto, cianobactérias destacam-se por promover crescimento vegetal, atuar como biocondicionadores, tolerar estresses abióticos e contribuir para a FBN.

Tais propriedades aumentam a produtividade e se alinham à agroecologia, conciliando sustentabilidade, altos rendimentos e manutenção da fertilidade do solo (Cassim et al., 2021; Álvarez et al., 2023; Jiménez-Ríos, 2024). Bioinsumos como algas e cianobactérias nutrem as plantas, fortalecem a saúde do solo e reduzem impactos do uso de fertilizantes minerais, integrando-se à agricultura regenerativa (Cassim et al., 2021; Álvarez et al., 2023; Jiménez-Ríos, 2024; Cherubin, 2024), apesar do potencial, dos altos custos, da variação na qualidade e da baixa uniformidade de cepas. Entretanto, avanços em biotecnologia e formulações estáveis representam uma oportunidade estratégica para consolidar seu uso de forma viável e sustentável na agricultura (Khan, 2018; Chisti, 2013).
Os bioinsumos são alternativas promissoras para uma agricultura sustentável, e as algas se destacam como biofertilizantes, promovendo crescimento vegetal, solubilização de nutrientes, FBN e maior tolerância a estresses abióticos. Seus benefícios incluem o desenvolvimento das plantas, a saúde e a qualidade do solo, aliando sustentabilidade, equilíbrio biológico, conservação ambiental e produtividade.
Apesar do potencial, a diversidade de espécies e cepas ainda desafia sua adoção em larga escala, exigindo políticas públicas, pesquisas e parcerias para desenvolver tecnologias e formulações que tornem seu uso mais eficiente, acessível e ambientalmente responsável.
Por Thiago Assis Rodrigues Nogueira, Rodrigo Silva Alves, Paulo Paschoalotto Marques e Franco Monici Fabrino (Universidade Estadual Paulista); Damiany Pádua Oliveira, Dágon Manoel Ribeiro e Simone Silva Vieira (Solubio Tecnologias Agrícolas)

Receba por e-mail as últimas notícias sobre agricultura